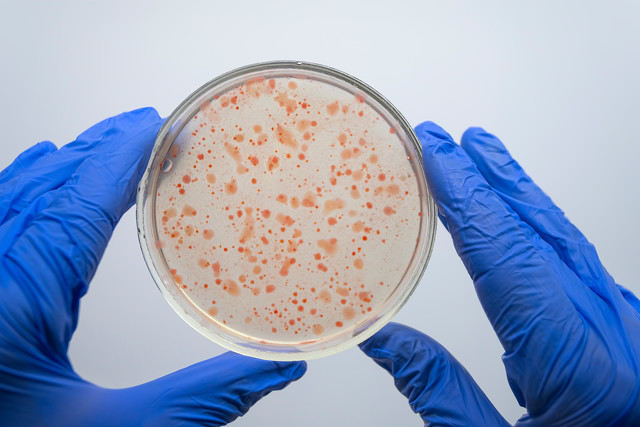

在科技飞速发展的当下,生物识别技术在银行卡领域的应用正逐渐成为行业关注的焦点。生物识别技术是指通过计算机与光学、声学、生物传感器和生物统计学原理等高科技手段密切结合,利用人体固有的生理特性,如指纹、脸像、虹膜等和行为特征,如笔迹、声音、步态等来进行个人身份的鉴定。那么,这项技术在银行卡领域的应用前景究竟怎样呢?
从安全性角度来看,生物识别技术为银行卡的使用提供了更高的保障。传统的银行卡认证方式,如密码和签名,存在被盗用和模仿的风险。而生物识别特征具有唯一性和不可复制性,大大降低了银行卡被盗刷的可能性。例如,指纹识别技术已经广泛应用于手机解锁,将其应用于银行卡支付,用户只需通过指纹验证即可完成交易,无需担心密码泄露的问题。虹膜识别技术则更加精准和安全,它能够快速准确地识别出个体的身份,即使是双胞胎也能轻松区分。这种高度的安全性将吸引更多用户选择使用具备生物识别技术的银行卡,从而推动其市场需求的增长。
在便捷性方面,生物识别技术也具有显著优势。用户无需再记忆复杂的密码,只需通过简单的生物特征识别操作,如刷脸、指纹验证等,就能快速完成银行卡的交易和身份验证。这不仅节省了时间,还提高了交易的效率。特别是在一些紧急情况下,如忘记密码或密码被盗用,生物识别技术能够迅速恢复用户对银行卡的控制权,保障资金安全。此外,随着移动支付的普及,生物识别技术与移动设备的结合将进一步提升银行卡的使用便捷性。用户可以通过手机随时随地进行银行卡的操作,无需携带实体卡片。
从市场趋势来看,生物识别技术在银行卡领域的应用前景广阔。随着消费者对支付安全和便捷性的要求不断提高,银行和金融机构纷纷加大了在生物识别技术方面的研发和投入。许多银行已经推出了具备指纹识别和人脸识别功能的银行卡,并取得了良好的市场反响。同时,政府也在积极推动生物识别技术的应用,出台了一系列相关政策和标准,为其发展提供了有力的支持。此外,随着技术的不断进步和成本的降低,生物识别技术的应用范围将不断扩大,不仅会应用于传统的银行卡,还可能拓展到信用卡、借记卡、电子钱包等多种金融产品中。
然而,生物识别技术在银行卡领域的应用也面临一些挑战。例如,生物识别数据的隐私保护问题是用户最为关注的焦点之一。银行和金融机构需要采取严格的安全措施,确保用户的生物识别数据不被泄露和滥用。此外,生物识别技术的准确性和稳定性也需要进一步提高,以避免因误识别或系统故障导致的交易失败和用户体验不佳。

为了更直观地比较不同生物识别技术在银行卡应用中的特点,以下是一个简单的表格:
生物识别技术 安全性 便捷性 准确性 成本 指纹识别 较高 高 较高 较低 人脸识别 高 高 较高 适中 虹膜识别 极高 较高 极高 较高
综上所述,生物识别技术在银行卡领域的应用前景十分乐观。虽然面临一些挑战,但随着技术的不断进步和市场的逐渐成熟,它将为银行卡行业带来巨大的变革和发展机遇。银行和金融机构应抓住这一机遇,积极推动生物识别技术的应用,为用户提供更加安全、便捷的支付体验。
313啦实用网



